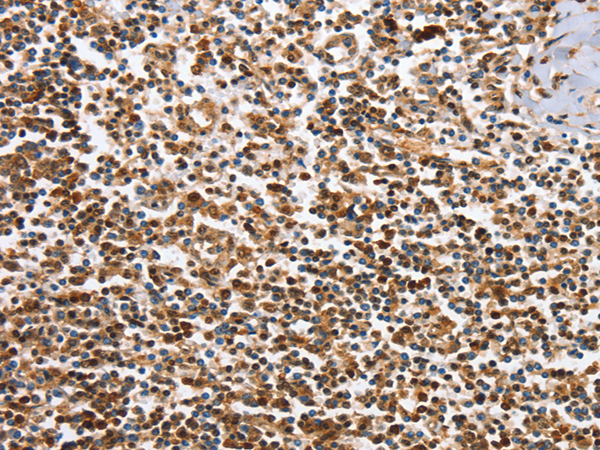

-
分类: 科研抗体货号: P07368别名: p62, IMP2, IMP-2, VICKZ2应用: WB反应种属: Human, Mouse
-
分类: 科研抗体货号: P07375别名: CDF; HGF; HSF; BSF2; IL-6; BSF-2; IFNB2; IFN-beta-2应用: WB,IHC反应种属: Human
-
分类: 科研抗体货号: P07367别名: IBP5应用: IHC反应种属: Human, Mouse, Rat
-
分类: 科研抗体货号: P07374别名: IL-2; TCGF; lymphokine应用: IHC反应种属: Human
-
分类: 科研抗体货号: P07366别名: BP-4; IBP4; IGFBP-4; HT29-IGFBP应用: IHC反应种属: Human, Mouse, Rat
-
分类: 科研抗体货号: P07372别名: CMF608应用: IHC反应种属: Human
-
分类: 科研抗体货号: P07364别名: INSULYSIN应用: WB,IHC反应种属: Human, Mouse, Rat
-
分类: 科研抗体货号: P07394别名: ASRT5; IRAKM应用: WB,IHC反应种属: Human, Mouse
-
分类: 科研抗体货号: P07393别名: ICSBP; IRF-8; ICSBP1; IMD32A; IMD32B; H-ICSBP应用: WB反应种属: Human, Mouse
-
分类: 科研抗体货号: P07392别名: p48; IRF-9; ISGF3; ISGF3G应用: WB,IHC反应种属: Human, Mouse

鄂公网安备42018502007531号
鄂公网安备42018502007531号

